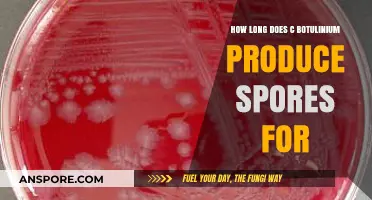
Understanding C. Botulinum's Sporulation Duration and Food Safety Risks

Installing *Spore*, the popular life simulation game developed by Maxis, typically takes between 15 to 30 minutes, depending on your system specifications and installation method. The process involves downloading or inserting the game disc, following the on-screen instructions, and waiting for the files to be copied and configured. Factors such as your computer's processing speed, available storage space, and whether you're installing from a physical disc or digital download can influence the total time. Once installed, *Spore* may require additional time for updates or patches to ensure optimal performance. Overall, the installation is straightforward and relatively quick, allowing players to dive into the game's creative and evolutionary gameplay without significant delay.
| Characteristics | Values |
|---|---|
| Installation Time (Typical) | 15-30 minutes (varies based on system specs and drive speed) |
| Game Size (Download) | ~4.5 GB |
| Installation Size (Disk Space) | ~6 GB |
| Platform | Windows (PC), Mac |
| Required Specifications | Minimum: 2 GHz CPU, 512 MB RAM, 6 GB HDD, 128 MB VRAM |
| Recommended Specifications | 3 GHz CPU, 1 GB RAM, 6 GB HDD, 256 MB VRAM |
| Installation Method | Digital (via Origin, Steam, or GOG) or Physical Disc |
| Additional Time Factors | Internet speed (for download), background processes, and updates |
| Patch/Update Time | 5-15 minutes (if updates are required after installation) |
| First Launch Time | 1-2 minutes (initial setup and configuration) |
| Compatibility | Windows XP/Vista/7/8/10, macOS (varies by version) |
| Known Issues | SecuROM DRM (older versions) may cause delays or errors |
| Uninstall Time | 5-10 minutes (depending on system speed) |
Explore related products
What You'll Learn
- System Requirements Check: Verify your PC meets minimum specs for smooth installation and gameplay
- Download Time: Depends on internet speed; faster connections reduce overall download duration significantly
- Installation Process: Typically takes 10-20 minutes, varying with system performance and setup
- Updates & Patches: Additional time required if updates or patches need to be installed post-setup
- Post-Install Setup: Includes configuring graphics, controls, and optional mods for enhanced experience

System Requirements Check: Verify your PC meets minimum specs for smooth installation and gameplay
Before diving into the installation process of *Spore*, a critical yet often overlooked step is ensuring your PC meets the minimum system requirements. This isn’t just a formality—it directly impacts how long the installation takes and whether the game runs smoothly afterward. For instance, *Spore* requires at least a 2.0 GHz processor, 512 MB of RAM, and 6 GB of free disk space. If your system falls short, installation could stall, or the game might crash during gameplay, turning a 30-minute setup into a frustrating troubleshooting session.
Analyzing the relationship between system specs and installation time reveals a clear pattern. A PC that exceeds the minimum requirements—say, with a 3.0 GHz processor and 4 GB of RAM—can install *Spore* in as little as 15 minutes. Conversely, a machine barely meeting the threshold might take twice as long, as the installer struggles to process files efficiently. This isn’t just about speed; it’s about preventing errors that could corrupt the installation, forcing you to start over.
To verify compatibility, follow these steps: open your PC’s System Properties (right-click the Start menu, select *System*), and check your processor speed, RAM, and available disk space. Compare these against *Spore*’s requirements, which can be found on the game’s official website or the installation disc’s packaging. If your GPU isn’t listed, use tools like GPU-Z to identify its model and ensure it supports Shader Model 2.0, another *Spore* prerequisite.
A common pitfall is assuming newer PCs automatically meet older game requirements. While *Spore* (released in 2008) isn’t graphically demanding by today’s standards, modern laptops with integrated graphics or low-power CPUs might still fall short. For example, a budget Chromebook or a lightweight ultrabook designed for browsing may lack the necessary processing power or dedicated graphics memory. Always double-check, even if your PC is recent.
The takeaway? A quick system requirements check isn’t just a preliminary step—it’s a time-saver. By ensuring your PC aligns with *Spore*’s needs, you avoid prolonged installations, potential errors, and post-setup performance issues. Think of it as laying a solid foundation for a house; skimp on the groundwork, and the entire structure suffers. Spend 5 minutes verifying your specs now, and save yourself hours of frustration later.
Nematodes vs. Milky Spore: Which Controls Grubs More Effectively?
You may want to see also

Download Time: Depends on internet speed; faster connections reduce overall download duration significantly
The time it takes to download *Spore* is a direct reflection of your internet speed. A 10 Mbps connection, for instance, can download a 5 GB file in about 68 minutes, while a 100 Mbps connection slashes that time to roughly 7 minutes. This disparity highlights the critical role of bandwidth in determining how quickly you can start playing. If you’re planning a gaming session, check your internet speed beforehand—tools like Ookla Speedtest can provide an accurate reading. Knowing your download rate allows you to estimate the wait time and plan accordingly, ensuring you’re not left staring at a progress bar when you could be exploring the game’s evolutionary sandbox.
Faster internet connections don’t just reduce download time; they transform the entire installation process into a seamless experience. For example, a gigabit connection (1 Gbps) can download *Spore* in under a minute, making the wait negligible. However, not everyone has access to such speeds. If you’re stuck with a slower connection, consider downloading during off-peak hours when network congestion is lower. Alternatively, if you’re frequently installing large games, upgrading your internet plan or switching to a fiber-optic provider could be a worthwhile investment. The key takeaway? Your internet speed isn’t just a number—it’s a determinant of how soon you can dive into the game.
Comparing download times across different speeds reveals a stark efficiency gap. At 5 Mbps, *Spore*’s 5 GB file takes over two hours to download, while at 50 Mbps, it’s down to 14 minutes. This comparison underscores the value of even modest upgrades in internet speed. For gamers on tight schedules, every minute counts. If you’re relying on a slower connection, prioritize closing bandwidth-heavy applications like streaming services or cloud backups during the download. This ensures maximum speed and minimizes frustration. Remember, the goal isn’t just to download *Spore*—it’s to do so without disrupting your day.
Finally, while internet speed is the primary factor, other variables can subtly influence download time. Router placement, Wi-Fi signal strength, and even the age of your hardware can affect performance. For optimal results, use an Ethernet connection instead of Wi-Fi, as it provides a more stable and faster data transfer. If Ethernet isn’t an option, position your router centrally and away from obstructions to improve signal quality. By addressing these secondary factors, you can maximize your internet speed’s potential and ensure the fastest possible download. After all, the quicker *Spore* installs, the sooner you can start crafting your own digital universe.
Does Anthrax Form Spores? Understanding the Deadly Bacteria's Survival Mechanism
You may want to see also

Installation Process: Typically takes 10-20 minutes, varying with system performance and setup
The installation time for Spore, a classic evolution-based simulation game, hinges on two critical factors: your system’s performance and its setup. On average, the process takes 10 to 20 minutes, but this range isn’t set in stone. A high-performance gaming rig with an SSD can shave this down to the lower end, while older systems with mechanical hard drives or cluttered setups may creep closer to 20 minutes or slightly beyond. Understanding these variables ensures you’re prepared for a smooth installation, avoiding frustration from unexpected delays.
For optimal results, follow these steps: 1) Close all unnecessary background applications to free up system resources. 2) Ensure your system meets the minimum requirements (e.g., 2.0 GHz CPU, 512 MB RAM, and 6 GB of free space). 3) If using a physical disc, clean it gently to avoid read errors. 4) For digital downloads, ensure a stable internet connection to prevent interruptions. These precautions streamline the process, minimizing the risk of errors or prolonged installation times.
Comparatively, Spore’s installation time is modest when stacked against modern AAA titles, which can take upwards of an hour due to massive file sizes and complex assets. However, it’s longer than lightweight indie games that often install in under 5 minutes. This places Spore in a middle ground, reflecting its balance between detailed gameplay mechanics and accessibility. Knowing this context helps manage expectations, especially if you’re transitioning between game types.
A practical tip for speeding up the process is to prioritize hardware upgrades if you’re consistently hitting the upper end of the installation time. Adding an SSD, for instance, can drastically reduce load times not just for installation but for gameplay as well. Alternatively, if upgrading isn’t an option, perform routine maintenance like disk defragmentation and clearing temporary files to optimize your system’s performance. These small adjustments can make a noticeable difference in installation efficiency.
In conclusion, while the 10-to-20-minute window is standard, it’s not immutable. By understanding the interplay between system performance and setup, taking proactive steps to optimize your environment, and contextualizing Spore’s installation time within the broader gaming landscape, you can ensure a hassle-free experience. Whether you’re revisiting this classic or discovering it for the first time, a little preparation goes a long way in getting you into the game faster.
Boost Your T-Score in Spore: Proven Strategies for Success
You may want to see also
Explore related products

Updates & Patches: Additional time required if updates or patches need to be installed post-setup
Installing *Spore* isn’t just about copying files to your system—it’s a process that can extend beyond the initial setup, particularly if updates or patches are required. These post-installation updates are essential for fixing bugs, improving performance, or adding new features, but they can significantly add to the total installation time. For instance, older versions of *Spore* often require multiple patches, each ranging from 50 MB to 2 GB in size, depending on the update. If your internet speed is 25 Mbps, downloading a 1 GB patch could take around 5–7 minutes, not including installation time. This additional step is often overlooked in time estimates but can double or triple the expected installation duration.
Consider the scenario where you’re installing *Spore* on a system with an outdated version. After the base game installs in roughly 30–45 minutes, the game launcher might prompt you to download and install several updates. Each patch typically takes 5–10 minutes to install, depending on your system’s processing speed. If there are five patches, you’re looking at an extra 25–50 minutes. To minimize this delay, check for available updates beforehand and download them manually if possible. Alternatively, ensure your system is connected to a stable, high-speed internet connection to streamline the process.
From a practical standpoint, planning for updates is as crucial as the installation itself. If you’re setting up *Spore* for a gaming session or event, allocate extra time for patches to avoid last-minute delays. For example, if the base installation is estimated at 45 minutes, add another 30–60 minutes for updates, especially if you’re working with a slower internet connection or an older PC. Pro tip: If you’re reinstalling *Spore* after a long time, visit the game’s official support page or forums to identify the latest patch version and download it separately to save time.
Comparatively, modern games often include updates in their initial download, but *Spore*, being an older title, follows a more traditional update model. This means the installation process is split into two phases: the base game and subsequent patches. While this can be frustrating, it also ensures you’re playing the most stable and feature-rich version of the game. For context, newer games might take 2–3 hours to install due to large file sizes, but *Spore*’s updates are smaller and more manageable, even if they require additional steps.
In conclusion, while the base installation of *Spore* might seem quick, updates and patches can extend the process significantly. By understanding this additional time requirement and planning accordingly, you can avoid frustration and ensure a smooth gaming experience. Treat updates as a necessary step rather than an afterthought, and you’ll be exploring the evolutionary wonders of *Spore* in no time.
Spore Probiotics for SIBO: Effective Relief or Just a Myth?
You may want to see also

Post-Install Setup: Includes configuring graphics, controls, and optional mods for enhanced experience
Once Spore is installed, the real customization begins. Post-install setup is where you tailor the game to your preferences, ensuring an optimal and personalized experience. This phase involves three key areas: graphics, controls, and mods. Each adjustment can significantly impact gameplay, so it’s worth investing time here.
Graphics Configuration: Balancing Beauty and Performance
Spore’s visual style is unique, blending simplicity with complexity, but its performance depends on your hardware. Start by launching the game and accessing the graphics settings. Adjust the resolution to match your monitor’s native resolution for sharpness. If you’re on older hardware, lower the texture quality and disable anti-aliasing to improve frame rates. Conversely, high-end systems can experiment with max settings and enable VSync for smoother visuals. Test changes in-game to find the sweet spot between aesthetics and performance.
Control Customization: Mastering the Interface
Spore’s default controls are intuitive but may not suit everyone. Head to the control settings to remap keys or adjust sensitivity. For example, reassigning camera controls to the mouse can enhance navigation during the creature and space stages. If using a controller, ensure it’s recognized by the game and calibrate the dead zones for precise movement. Pro tip: save multiple control profiles if you switch between keyboard/mouse and controller setups.
Optional Mods: Elevating the Experience
Mods can breathe new life into Spore, adding features, fixing bugs, or altering gameplay mechanics. Start with beginner-friendly mods like "Dark Injection," which enhances graphics and expands content, or "BetterSpore," which improves UI and mechanics. Download mods from trusted sources like the Spore ModAPI or NexusMods. Installation typically involves extracting files into the game’s directory, but always back up your save files first. Experiment cautiously—some mods may conflict or require specific compatibility patches.
Time Investment: Planning Your Setup
Post-install setup can take anywhere from 15 minutes to an hour, depending on your goals. Graphics and controls usually require 10–20 minutes, while mod installation and testing can add another 10–40 minutes. If you’re new to modding, allocate extra time to troubleshoot. The payoff? A game that feels tailor-made for your playstyle, extending Spore’s longevity and replayability.
Can Humans Generate Cryptococcus Spores? Unraveling the Science Behind Cryptococcal Infections
You may want to see also
Frequently asked questions
The installation time for Spore on a PC typically ranges from 10 to 30 minutes, depending on your system specifications and the speed of your optical drive or download connection.
Yes, the installation time can vary slightly between the physical disc version and the digital download version. Digital downloads may take longer if your internet speed is slow, while the disc version depends on your drive’s read speed.
Yes, factors such as outdated hardware, insufficient system resources, or background processes running on your computer can slow down the installation process. Ensuring your system meets the minimum requirements and closing unnecessary applications can help speed up installation.